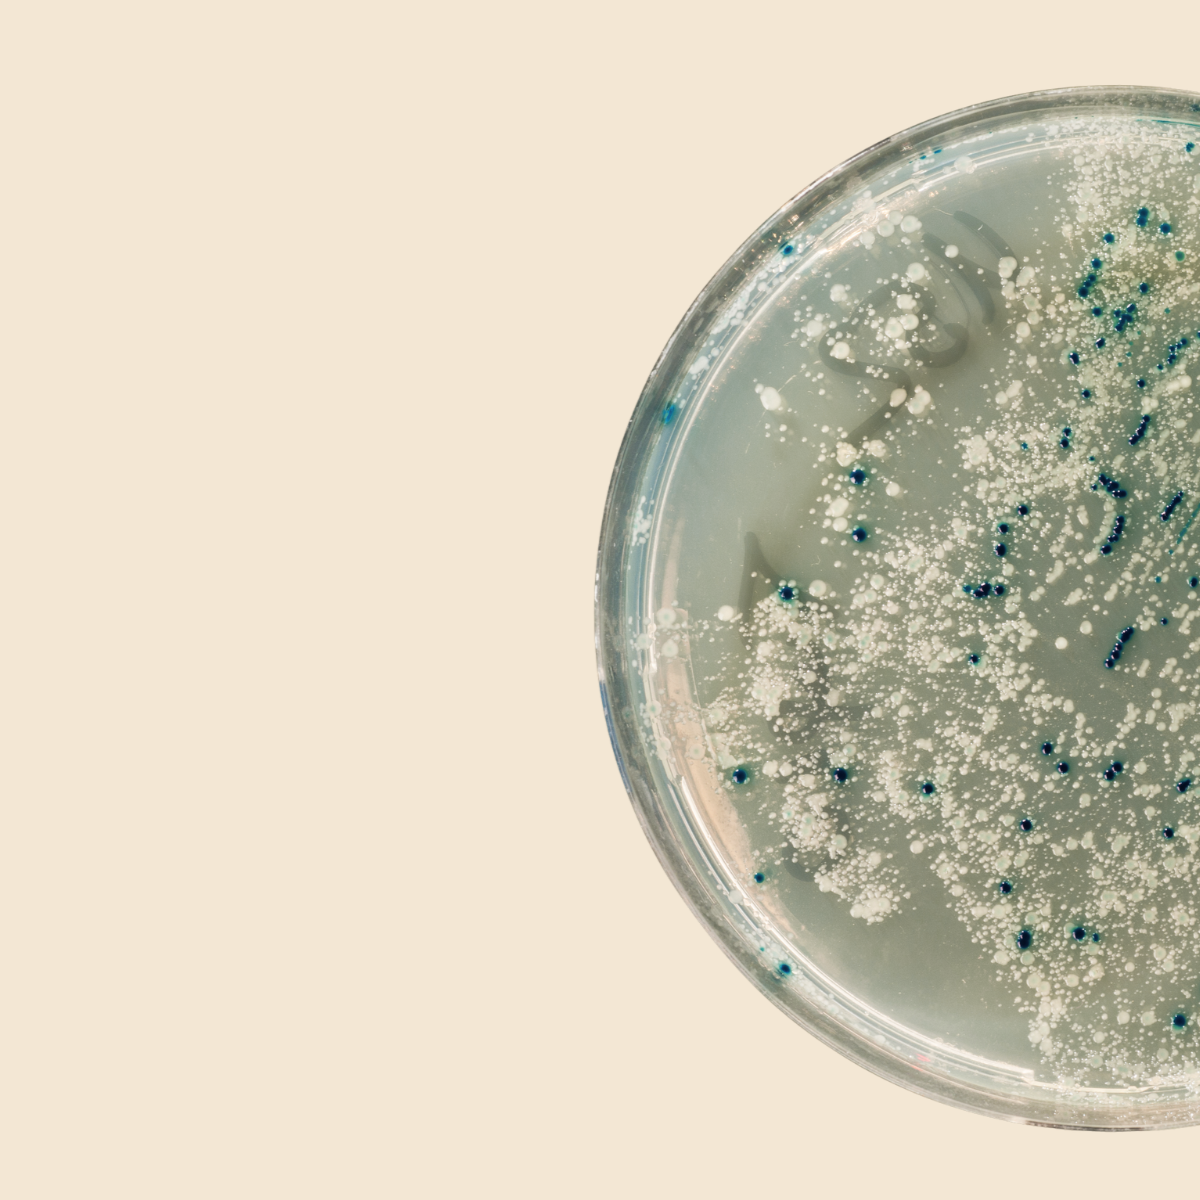

We target the root cause, not the symptom

Acne is caused by live bacteria on the skin.
Use this text to share information about your brand with your customers. Describe a product, share announcements, or welcome customers to your store.
TUUMBIOME Acne Care Phage Gel is a science-led skincare solution powered by active bacteriophages — natural microorganisms that selectively attack the harmful bacteria most commonly associated with acne.
Phages target the bad bacteria that are most responsible for causing acne.